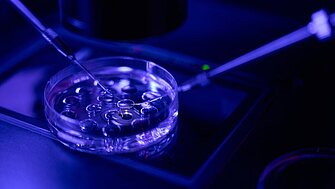
PI Ceramic Precision and Innovation in Modern Reproductive Medicine

Eine Methode der künstlichen Befruchtung ist ICSI. Die piezoaktivierte Methode (Piezo-ICSI) bietet neue Chancen. So treibt beim Piezo-ICSI-Verfahren ein aktiviertes Piezoelement die Mikrokapillare aus Glas mit dem aufgenommenen Spermium in einer präzisen Bewegung vorwärts, sodass die Hülle und die Zellmembran der Eizelle durchdrungen werden können. Anschließend kann die Spitze der Mikrokapillare vorsichtig in die Mitte des Zytoplasmas eingeführt werden, um das Spermium dort zu platzieren.
Mehr erfahrenAuthor: Dr. Franziska Buch
Präzision und Innovation in der modernen Reproduktionsmedizin
Piezo-ICSI ermöglicht gute Erfolgsraten bei künstlicher Befruchtung
Präzision und Innovation in der modernen Reproduktionsmedizin
Piezo-ICSI ermöglicht gute Erfolgsraten bei künstlicher Befruchtung
· Dr. Franziska Buch
Eine Methode der künstlichen Befruchtung ist ICSI. Die piezoaktivierte Methode (Piezo-ICSI) bietet neue Chancen. So treibt beim Piezo-ICSI-Verfahren ein aktiviertes Piezoelement die Mikrokapillare aus Glas mit dem aufgenommenen Spermium in einer präzisen Bewegung vorwärts, sodass die Hülle und die Zellmembran der Eizelle durchdrungen werden können. Anschließend kann die Spitze der Mikrokapillare vorsichtig in die Mitte des Zytoplasmas eingeführt werden, um das Spermium dort zu platzieren.
Mehr erfahren